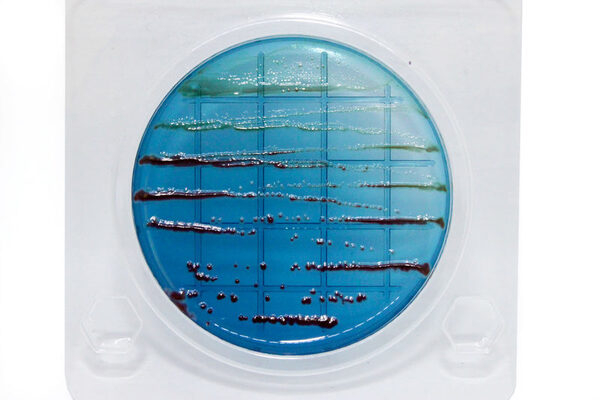
?

Мы разошлем вашу новость, анонс или пресс-релиз в более 1000 СМИ
Мы опубликуем вашу новость в самых авторитетных и профильных изданиях России и СНГ
Предоставим подробный отчет, с ссылками на все публикации
Популярные новости
18.02.2020 Медицина и фармацевтика
Как найти синегнойную палочку в косметике?
Синегнойная палочка (лат. Pseudomonas aeruginosa) обширно распространена в окружающей среде, может также встречаться в организмах человека и животных.
Считается очень опасной бактерией для человека, так как заражение синегнойной палочкой приводит к множественным инфекциям, которые очень сложно лечить – многие антибиотики на нее попросту не действуют.
Синегнойная палочка одна из самых серьезных возбудителей внутрибольничной инфекции. Но даже если вы никогда не лежали в больнице, или, побывав в стационаре, не подхватили там эту бактерию, велик шанс встретиться с ней и вне больничных стен.
Где же прячется синегнойная палочка? Как это ни странно, в косметике. Косметическая продукция давно и прочно вошла в нашу жизнь, мы даже не замечаем, что пользуемся ей ежедневно. Так что опасность может таиться и в привычных кремах, губной помаде и т.д. В косметические препараты синегнойная палочка может попадать разными путями – как через сырье, так и через руки персонала.
Для проверки косметических средств используются экспресс-тесты НПО «Альтернатива» сделали за вас, разработав и выпустив «Петритесты». Просто следуйте пошаговой инструкции и первые результаты можно визуализировать уже через 12 часов, а подтвержденные – через 24-36 часов.
Безусловно, «Петритест» поможет определить синегнойную палочку не только в парфюмерно-косметической продукции, но и в принципе везде, где вы заподозрите её наличие.
Экономичность, эффективность, оперативность и большое разнообразие «Петритестов» – вот причина, по которой все больше и больше организаций и частных лиц пользуются нашими экспресс-тестами.
Отметим также, что питательная среда в тесте на «синегнойку» имеет дифференцирующие свойства и предназначена для выявления пигмента пиоцианин.